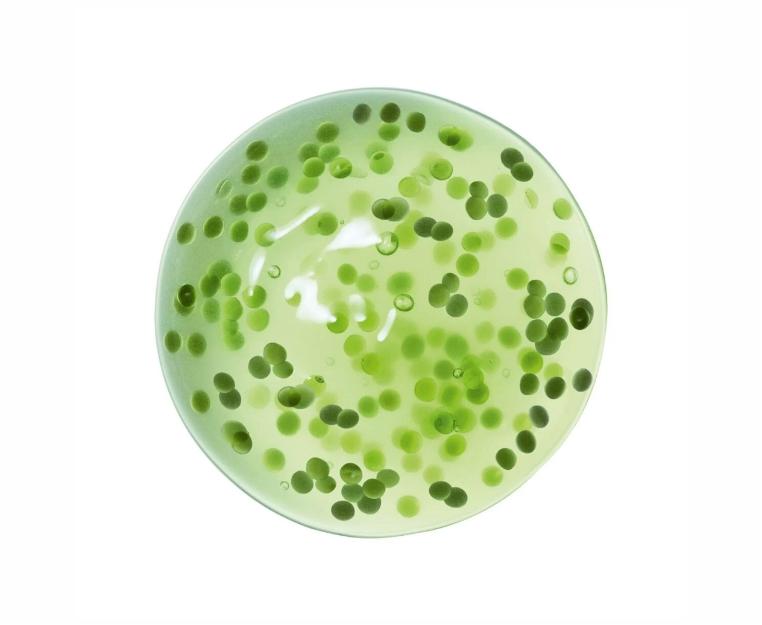

Сыворотка для лица
Armani CREMA NERA REVISCENTALIS META CONCENTRATE Концентрированная восстанавливающая сыворотка
Артикул: 4935421748216
Подтвердите ваш город
Сыворотка для лица Armani CREMA NERA REVISCENTALIS META CONCENTRATE Концентрированная восстанавливающая сыворотка
Reviscentalis Meta Concentrate – новая антивозрастная сыворотка от Crema Nera, обеспечивающая качественно иной уровень восстановления кожи. Ее уникальная формула основана на мощном действии метаболитов «воскресающего» растения Myrothamnus flabellifolia. Вдохновившись невероятной способностью растения к самовосстановлению, специалисты лабораторий Armani beauty создали высококонцентрированный экстракт Reviscentalis™ и увеличили его содержание в сыворотке до 200%, получив драгоценный эликсир нового поколения, который стимулирует клеточный метаболизм и способствуют восстановлению кожи. Мощное пробуждающее действие средства связано с его одновременной работой на трех клеточных уровнях:
Очищение – повышение эффективности процесса выведения токсинов на 82 %*, что приводит к увеличению уровня жизненной энергии кожи.
Защита – снижение степени окисления компонентов клеток на 31 %*.
Регенерация – улучшение клеточного метаболизма (синтеза гликозаминогликанов) на 142 %* и увеличение выработки коллагена на 322 %*.
Видимый результат наступает уже с первого применения. Мгновенно кожа лица становится более упругой, мягкой и сияющей. При регулярном использовании ее текстура становится заметно более гладкой и однородной, а морщины менее выраженными. Сыворотка Reviscentalis Meta Concentrate создана на основе инновационной методики инкапсуляции, которая позволяет бережно сохранить и в нужный момент высвободить все самые ценные ингредиенты, обеспечивая беспрецедентную эффективность.
* По результатам тестирования in vitro.
Мне нужна помощь